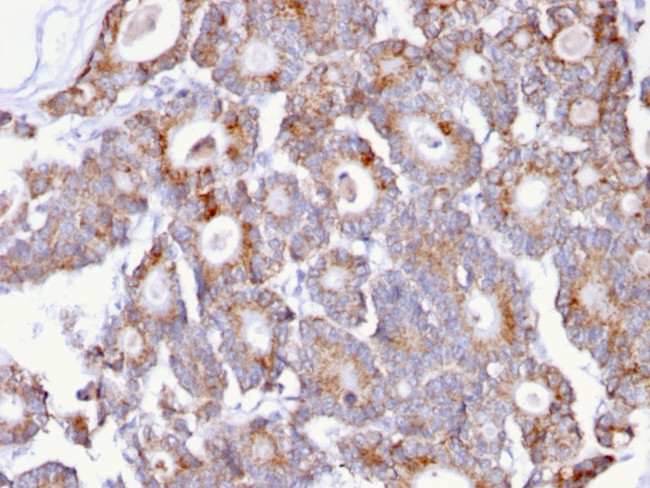
Thomsen-Friedenreich Antigen/CD176 (Pan Carcinoma Marker) Antibody in Immunohistochemistry (Paraffin) (IHC (P))

Search
NeoBiotechnologies
Thomsen-Friedenreich Antigen/CD176 (Pan Carcinoma Marker) Monoclonal Antibody (A84-A/F10)
{{$productOrderCtrl.translations['antibody.pdp.commerceCard.promotion.promotions']}}
{{$productOrderCtrl.translations['antibody.pdp.commerceCard.promotion.viewpromo']}}
{{$productOrderCtrl.translations['antibody.pdp.commerceCard.promotion.promocode']}}: {{promo.promoCode}} {{promo.promoTitle}} {{promo.promoDescription}}. {{$productOrderCtrl.translations['antibody.pdp.commerceCard.promotion.learnmore']}}



Please note: We are reviewing Western blot images included in the antibody testing data in our catalog, including those provided by third parties. Unless expressly labeled or annotated as “raw-unedited”, Western blot images included in the antibody testing data in our catalog may have been edited, optimized or otherwise adjusted for presentation.
产品信息
MSM4-1294-P1BX
种属反应
宿主/亚型
分类
类型
克隆号
抗原
偶联物
形式
浓度
规格
纯化类型
保存液
内含物
保存条件
运输条件
靶标信息
The Thomsen-Fridenreich antigen acts as an oncofetal antigen, with low expression in normal adult tissues but increasing to fetal levels of expression in hyperplasia or malignancy. It is considered as a pan-carcinoma marker. This gene is a member of the mucin family and encodes a membrane bound, glycosylated phosphoprotein. The protein is anchored to the apical surface of many epithelia by a transmembrane domain, with the degree of glycosylation varying with cell type. It also includes a 20 aa variable number tandem repeat (VNTR) domain, with the number of repeats varying from 20 to 120 in different individuals. The protein serves a protective function by binding to pathogens and also functions in a cell signaling capacity. Overexpression, aberrant intracellular localization, and changes in glycosylation of this protein have been associated with carcinomas. Multiple alternatively spliced transcript variants that encode different isoforms of this gene have been reported, but the full-length nature of only some has been determined.
仅用于科研。不用于诊断过程。未经明确授权不得转售。
篇参考文献 (0)
生物信息学
蛋白别名: TFA